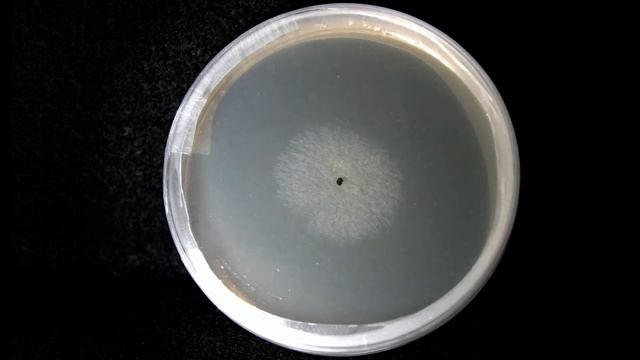

Автор: Грибная ферма
Plant Pathogen Fungi Timelapse

infected from Russia

CORDYCEPS MILITARIS : les bienfaits.

Старое место.

ПЯТЕРКА ЗА КРУТОСТЬ, КОТОРУЮ МЫ ЗАБЫЛИ.....

Строки позовної давності.

Вылазка в лес ( поиск грибов)

Здесь сделаем ГНБ прокол ☝️

Обзор на новый скин кээс:хо
![~ Cordyceps, Cordyceps everywhere! ~ [ The Last of Us - PART 3 ] смотреть онлайн](https://pic.rutubelist.ru/video/2025-02-03/2e/b3/2eb3574dfa448e4e8d07881c19de491f.jpg?size=m)
~ Cordyceps, Cordyceps everywhere! ~ [ The Last of Us - PART 3 ]

Буровая установка гидравлическая

Горные места маслят ))поход март 31

Грибы есть! Сколько набрали?

Лайфхаки: как собрать грибы и не заблудиться

покладено

БЕЗ ДАТЫ — Танцуй (lyric video)

Збираю білі гриби на Поліссі

"Красива весна" у виконанні Коваль Надії

А4 Тает Срок в маинкрафт

How to Get Rid of Candida and Other Superbugs #63

#Drawing a #picture of a #mushroom #forchildren / #Рисуем #картинку #гриб #длядетей

Повна Веселка м. Радехів 18 травня 2016. 4k. . Full Rainbow. May 18, 2016.

Разведка

Pastaiga pa mežu
За каждым успешным каналом стоит личность, идея и сотни часов кропотливого труда. Если вы здесь, значит, автор «Грибная ферма» уже сумел зацепить ваше внимание своим уникальным стилем или подачей. А мы на RUVIDEO позаботились о том, чтобы вы могли изучить весь архив его работ в максимально комфортных условиях — без лишней суеты и преград.
Почему за работами канала «Грибная ферма» так интересно наблюдать? Всё просто: это честный контент, который находит отклик в сердцах зрителей. На нашем ресурсе вы можете смотреть онлайн все видео любимого автора бесплатно и в хорошем качестве. Нам важно, чтобы вы видели каждую деталь и слышали каждый нюанс, поэтому мы используем только стабильные плееры из открытых источников Rutube.
Следите за новинками канала, пересматривайте старые шедевры и открывайте для себя новые грани творчества «Грибная ферма». Мы постоянно обновляем ленту, чтобы у вас под рукой всегда были самые свежие выпуски. Никаких сложных регистраций — только вы и творчество, которое вдохновляет. Приятного вам путешествия по миру авторского контента на RUVIDEO!
Видео взято из открытых источников Rutube. Если вы правообладатель, обратитесь к первоисточнику.